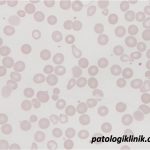
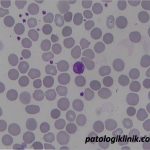
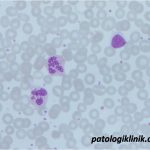
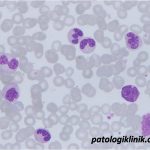
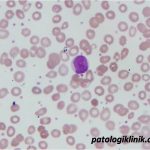
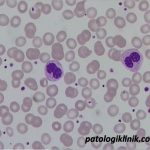
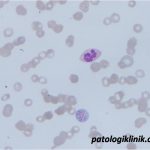

Gambaran Apusan Darah Tepi pada Myelodysplastic Syndrome (MDS)
Gambaran apusan darah tepi yang bisa ditemukan pada pasien MDS di antaranya:
1.Seri eritrosit:
- anisositosis
- poikilositosis
- basophilic stippling
2.Seri leukosit
- pseudo Pelger-Huet
- hipogranulasi netrofil
- hipersegmentasi netrofil
- sel blast
3.Seri trombosit
- anisositosis
- giant platelet
Sumber:
Malcovati L, Lindberg EH, BowenD. 2013. Diagnosis and treatment of primary myelodysplastic syndromes in adults: recommendations from the European LeukemiaNet. Blood 122(17); 2943-2963